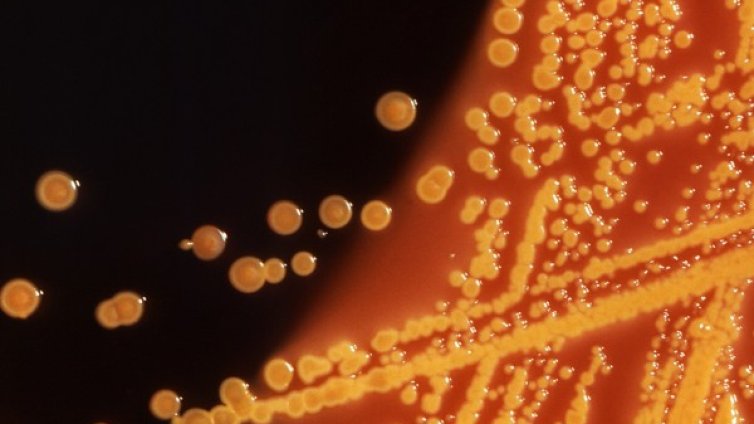
Светът пред опасност: Опасна бактерия пълзи в болници

Новини
-
Сделките с имоти в големите градове падат и през второто тримесечие
-
България излиза със 70 състезатели в Световна купа „Варна“ 2026
-
Назначено е ново ръководство на "Български ВиК холдинг"
-
Ердоган похвали отношението на България към турската общност на среща с Радев
-
Нито чули, нито видели: Службите у нас нямат информация дали патриарх Кирил е агент на КГБ
-
Зелен "експеримент"? Индия негодува заради бензина, който чупи колите им (СНИМКИ+ВИДЕО)
-
Когато спестяването вече не е достатъчно: депозитът или активното управление на капитала?
-
Половин милион загинали, 40 кв. км. придобита територия: Равносметката за Путин в цифри
-
Хотелиери и ресторантьори в Созопол: Сезонът започна повече от успешно
-
Турция забрани къпането в Черно море
-
Шокираща версия за смъртта на принцеса Даяна – говори бивш агент на MИ-6
-
Белград илюстрира най-големия страх на ЕС - кандидат, който не иска да се промени
-
РСМ след Мицкоски: По-далеч от ЕС, по-близо до Орбан
-
Украйна привлича чуждестранни бойци с пари, но ги задържа трудно
-
Половин милион загинали, 40 кв. км. придобита територия: Равносметката за Путин в цифри
-
На фона на кризата с горивата: Продажбите на коне в Русия скочиха
-
Демерджиев за полетите на Пеевски и Атанасова: Има още много, които съвпадат по дати и участници
-
Слаб старт на сезона по Южното Черноморие, отчитат 30% спад
-
Емрах за гафа в Созопол: Всеки ден се случват най-лошите работи в нашата държава
-
Зеленски: Боевете за Константиновка продължават
-
Борисов: С казуса "Пеевски - Атанасова" местят фокуса от бюджета

Какво е положението на Турция в НАТО в момента?
Какво е положението на Турция в НАТО в момента?  Темпът на растеж в сектора на услугите в САЩ се охлажда през юни
Темпът на растеж в сектора на услугите в САЩ се охлажда през юни  САЩ ще възобновят ротацията на войски в Полша
САЩ ще възобновят ротацията на войски в Полша  София осигурява спешно близо 42 млн. евро за обновяване на градския транспорт
София осигурява спешно близо 42 млн. евро за обновяване на градския транспорт  Защо неравенството в доходите между половете в Европа се задълбочава след пенсиониране?
Защо неравенството в доходите между половете в Европа се задълбочава след пенсиониране?  Макс Гурвиц: Миналата година българските стартъпи са привлекли около 230 млн. евро инвестиции
Макс Гурвиц: Миналата година българските стартъпи са привлекли около 230 млн. евро инвестиции 
 Централна прогноза
Централна прогноза  Глоба от €20 за Емрах заради карането на кола в пешеходната зона на Созопол (ВИДЕО)
Глоба от €20 за Емрах заради карането на кола в пешеходната зона на Созопол (ВИДЕО)  България излиза със 70 състезатели в Световна купа "Варна" 2026
България излиза със 70 състезатели в Световна купа "Варна" 2026  Закани за отмъщение срещу Тръмп белязаха погребалното шествие на Хаменей в Иран
Закани за отмъщение срещу Тръмп белязаха погребалното шествие на Хаменей в Иран  ДПС със сигнал срещу Демерджиев до Европол и Интерпол заради "PNR-гейт"
ДПС със сигнал срещу Демерджиев до Европол и Интерпол заради "PNR-гейт"  Хакерска атака в Google Maps: Преименуваха президентския дворец в Полша на "Дворец на хулиганите"
Хакерска атака в Google Maps: Преименуваха президентския дворец в Полша на "Дворец на хулиганите" 
 Бивш на Левски и ЦСКА ще рита във Втора лига
Бивш на Левски и ЦСКА ще рита във Втора лига  Исторически момент за ЦСКА: Отборът прекрачи прага на новата "Армия" + ВИДЕО
Исторически момент за ЦСКА: Отборът прекрачи прага на новата "Армия" + ВИДЕО  ПСЖ обяви любопитен трансфер
ПСЖ обяви любопитен трансфер  Еуфория на "Герена": Злато за Левски заради шампионската титла
Еуфория на "Герена": Злато за Левски заради шампионската титла  ФИФА отряза Белгия: Отхвърли жалбата срещу помилването на Балогун
ФИФА отряза Белгия: Отхвърли жалбата срещу помилването на Балогун  ЦСКА се размина с Десподов, националът остава в ПАОК
ЦСКА се размина с Десподов, националът остава в ПАОК 
 Мощният портал на 7/7 отключва късмета за 3 зодии
Мощният портал на 7/7 отключва късмета за 3 зодии  Протеин за жените – колко наистина ви е нужен
Протеин за жените – колко наистина ви е нужен  Дневен хороскоп за 7 юли, вторник
Дневен хороскоп за 7 юли, вторник  Как да рестартирате дома си за един ден
Как да рестартирате дома си за един ден  Любовен хороскоп за 6 – 12 юли
Любовен хороскоп за 6 – 12 юли  „Вътрешен вик“ от Янка Трачук
„Вътрешен вик“ от Янка Трачук 
 продава, Двустаен апартамент, 55 m2 Бургас област, к.к.Слънчев Бряг, 72000 EUR
продава, Двустаен апартамент, 55 m2 Бургас област, к.к.Слънчев Бряг, 72000 EUR  продава, Тристаен апартамент, 107 m2 Пловдив, Остромила, 330000 EUR
продава, Тристаен апартамент, 107 m2 Пловдив, Остромила, 330000 EUR  продава, Двустаен апартамент, 98 m2 Бургас област, к.к.Слънчев Бряг, 112000 EUR
продава, Двустаен апартамент, 98 m2 Бургас област, к.к.Слънчев Бряг, 112000 EUR  продава, Къща, 55 m2 Кюстендил област, гр.Кочериново, 30000 EUR
продава, Къща, 55 m2 Кюстендил област, гр.Кочериново, 30000 EUR  продава, Парцел, 850 m2 Шумен област, с.Кюлевча, 32000 EUR
продава, Парцел, 850 m2 Шумен област, с.Кюлевча, 32000 EUR  продава, Четиристаен апартамент, 120 m2 Шумен, Широк център, 300000 EUR
продава, Четиристаен апартамент, 120 m2 Шумен, Широк център, 300000 EUR 
 България излиза със 70 състезатели в Световна купа „Варна“ 2026
България излиза със 70 състезатели в Световна купа „Варна“ 2026  УЕФА издига свой кандидат за шеф на ФИФА
УЕФА издига свой кандидат за шеф на ФИФА  Фондация „Стилиян Петров“ ще дари медицинска апаратура на онкологичен център в Бургас
Фондация „Стилиян Петров“ ще дари медицинска апаратура на онкологичен център в Бургас  Спипаха варненец с 1,69 промила на АМ "Хемус"
Спипаха варненец с 1,69 промила на АМ "Хемус"  Хванаха за ден 35-ма шофьори с алкохол или наркотици
Хванаха за ден 35-ма шофьори с алкохол или наркотици  Кабинетът предлага таван от 20% за увеличението на таксите за платено обучение във вузовете
Кабинетът предлага таван от 20% за увеличението на таксите за платено обучение във вузовете 
 Астероидът Апофис ще премине опасно близо до Земята през 2029 г.
Астероидът Апофис ще премине опасно близо до Земята през 2029 г.  Бивша служителка обвини НАСА, че премахва НЛО от сателитни снимки преди публикуване
Бивша служителка обвини НАСА, че премахва НЛО от сателитни снимки преди публикуване  Към Луната и Марс: Технологиите и откритията, които ще променят света в следващите 25 години
Към Луната и Марс: Технологиите и откритията, които ще променят света в следващите 25 години  Най-високите тропически дървета в света имат сложна защита срещу суша
Най-високите тропически дървета в света имат сложна защита срещу суша  Китайската сонда „Тянуън-2“ достигна астероид на 1 млрд. км от Земята
Китайската сонда „Тянуън-2“ достигна астероид на 1 млрд. км от Земята  Загадъчна цивилизация е владяла Андите преди инките
Загадъчна цивилизация е владяла Андите преди инките